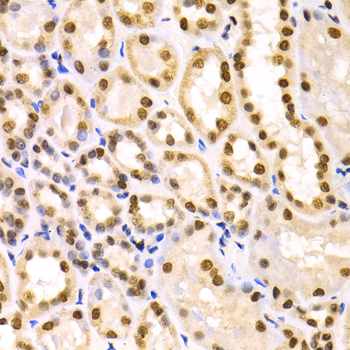
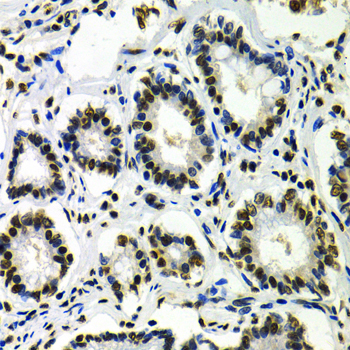

For quotations, please use our online quotation form, and you may also contact us by
service@kendallscientific.com
+1-888.733.6849 (Toll-free)
+1-617.299.7367 (Int’l))
+1-888.733.6849
Our customer service representatives are available 24 hours, Monday through Friday to assist you.| Reactivity | Human Mouse Rat |
| Tested applications | WB IHC IF |
| Recommended Dilution | WB 1:500 - 1:2000 IHC 1:50 - 1:200 IF 1:50 - 1:200 |
| Calculated MW | 53kDa |
| Observed MW | Refer to Figures |
| Immunogen | Recombinant protein of human IKZF1 |
| Storage Buffer | Store at -20℃. Avoid freeze / thaw cycles. Buffer: PBS with 0.02% sodium azide, 50% glycerol, pH7.3. |
| Concentration | k |
| Synonym | IK1; LYF1; hIk-1; IKAROS; PRO0758; ZNFN1A1; Hs.54452; |

Western blot analysis of extracts of BT474 cell lines, using IKZF1 antibody.

Immunohistochemistry of paraffin-embedded rat spleen using IKZF1 antibody at dilution of 1:100 (x400 lens).
Immunohistochemistry of paraffin-embedded human kidney using IKZF1 antibody at dilution of 1:100 (x400 lens).

Immunohistochemistry of paraffin-embedded human kidney cancer using IKZF1 antibody at dilution of 1:100 (x400 lens).
Immunohistochemistry of paraffin-embedded human gastric cancer using IKZF1 antibody at dilution of 1:100 (x400 lens).

Immunofluorescence analysis of U2OS cell using IKZF1 antibody. Blue: DAPI for nuclear staining.
Ikaros family proteins, characterized by the presence of an N-terminal zinc finger DNA-binding domain and a C-terminal dimerization domain, belong to the Kruppel transcription factor superfamily. The Ikaros family includes Ikaros, Aiolos, Helios, and possibly EOS and Pegasus (1). They can form homodimers and heterodimers with other members of the Ikaros family. Due to differential splicing, multiple isoforms can be generated and some behave in a dominant negative manner upon dimerization (2).Ikaros, also known as Ikaros family zinc finger protein 1 (IKZF1) and Lymphoid transcription factor 1 (LYF-1), is expressed abundantly in blood cells. Genetic studies in mice demonstrate that Ikaros is important for the normal development of B, T, natural killer, and dendritic cells, and that it functions as a tumor suppressor (3,4). Research studies have shown that imbalanced expression of different Ikaros isoforms, as well as deletions of Ikaros are associated with hematologic malignancies in humans (5-7).
N/A